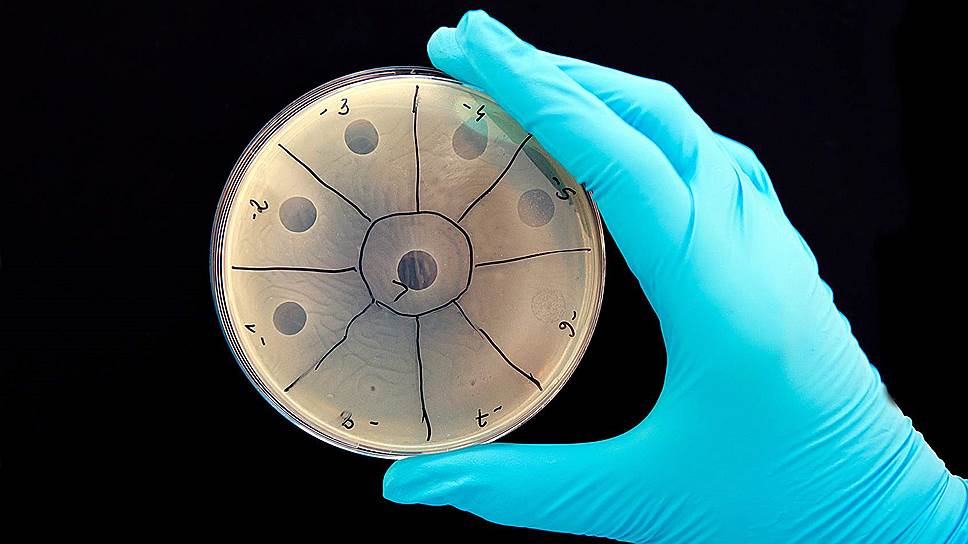

Ученые Тель-Авивского университета придумали, как можно победить бактерии, устойчивые к антибиотикам. Для этого они использовали естественных врагов бактерий — вирусы-бактериофаги. Модифицированные вирусы, проникнув в бактерию, "убирают" из ее ДНК гены устойчивости к антибиотикам и "добавляют" гены устойчивости к вирусам. В итоге получают шанс размножиться только бактерии чувствительные к антибиотикам. "Мы дали преимущество при естественном отборе штаммам, которые легко уничтожимы антибиотиками",— говорит генетик Идо Йосеф. На основе измененных вирусов ученые уже создали препарат для дезинфекции в больницах.
Фото: Fotolia / PhotoXPress

